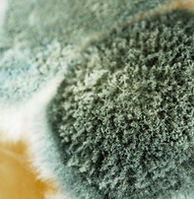
Mold during home inspection

Cosmic Property Inspections, LLC
Town of Longmeadow MA
Trusted Home Inspections in Longmeadow, MA
Welcome to Cosmic Property Inspections, your premier source for home inspections in Longmeadow, MA. Longmeadow, Massachusetts offers a rich history and a picturesque residential setting just south of Springfield. The area was originally explored by William Pynchon, a Puritan leader and Treasurer of the Massachusetts Bay Company, who sought to establish a trading post and agricultural settlement. Drawn by fertile meadows near the Connecticut and Agawam Rivers—and the profitable beaver trade—Pynchon secured the land, known by Native Americans as “Masacksic” or “the long meddowe.”
Today, Longmeadow is celebrated for its timeless charm, colonial architecture, and strong community values. The town is also known for its contribution to American architecture through Longmeadow brownstone, used in iconic buildings such as Princeton University's library.
What Makes Longmeadow Unique:
• Historic Homes: A significant number of well-preserved 18th and 19th-century homes line the town green and streets like Birnie Road.
• Town Green: A central park-like stretch, the town green serves as a historic hub and community gathering space, featuring mature trees and a war memorial.
• Longmeadow Brownstone: Mined locally, this distinctive stone was used in numerous prominent structures across the United States.
• Johnny Appleseed Connection: Folklore ties Johnny Appleseed to Longmeadow through his wife, Lucy Cooley, who once lived in the town.
• Exclusive Character: With no commercial industry and strict zoning laws, Longmeadow maintains a quiet, residential atmosphere ideal for families and professionals alike.
Whether you're considering a move or simply exploring Western Massachusetts, Longmeadow blends small-town tranquility with deep historical roots—making it a standout community in the Pioneer Valley.
What Makes Longmeadow Unique:
Longmeadow offers a variety of housing types, and we’re equipped to inspect them all:
-
Historic Colonial Homes – Assessing original beams, stone foundations, and early electrical retrofits
-
Condos & Townhomes – Comprehensive interior and common area evaluations
-
Luxury Properties – In-depth systems analysis and attention to custom features
-
Investment & Rental Properties – Identifying issues affecting habitability and long-term value
Neighborhoods We Serve in Longmeadow
We proudly inspect homes across Longmeadow, including:
-
The Green – Home to historic properties and iconic brownstone architecture
-
Birnie Road Area – Quiet residential streets lined with family-friendly homes
-
Maple Road – A blend of mid-century and newer builds near the Connecticut border
-
Williams Street Corridor – Desirable properties with proximity to parks and schools
Whether you're in the heart of Longmeadow or on its peaceful edges, we’re here to support your home journey.
Local Real Estate Trends in Longmeadow, MA
Home values in Longmeadow remain strong due to limited inventory, historic charm, and excellent public schools.
Many homes in the area feature:
• Original hardwood floors and masonry
• Oil or gas heating systems requiring regular maintenance
• Aging roofs and foundations needing professional review
A home inspection can help buyers avoid costly surprises and give sellers an edge when listing.
Schedule Your Longmeadow Home Inspection Today
Call 413-302-2665 or book your inspection online to get started. Trust Cosmic Property Inspections for prompt, professional service rooted in local expertise.
FAQs
Do you provide home inspections for historic properties in Longmeadow?
Yes. Longmeadow is known for its historic homes, and we have extensive experience inspecting older properties. We understand the unique systems and materials used in 18th and 19th-century construction and provide detailed assessments tailored to these homes.
What types of inspections do you offer in Longmeadow?
We offer comprehensive home inspections, including buyer and pre-listing inspections, radon testing, termite/WDI inspections, mold evaluations, thermal imaging, and many others.
How soon can I schedule a home inspection in Longmeadow?
We can often schedule inspections within 72 hours, depending on availability. Contact us directly for the most accurate scheduling information—we’ll do our best to accommodate your timeline. 413-302-2665
Are you licensed and familiar with Massachusetts standards?
Yes. I am licensed in Massachusetts and follow all state and InterNACHI Standards of Practice. We also stay current on building trends and issues specific to Longmeadow homes.
.jpg)

.png)

.jpg)


_edited.jpg)
